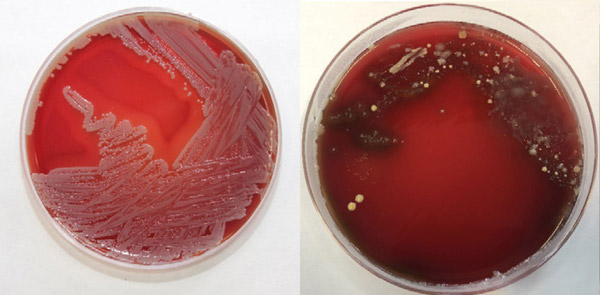
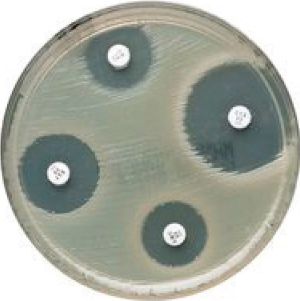

Panels for antimicrobial susceptibility testing of bovine mastitis pathogens
Alan Johnson MVB MVM writes about the development by the DAFM and AHI of antimicrobial susceptibility testing panels for bovine mastitis pathogens and explains why these core panels are important to therapeutic decision-making
A common task in dairy practice is the collection and submission of a milk sample for microbial culture and antimicrobial susceptibility testing (AST). Bacteria are the principal cause of bovine mastitis and identifying the causative organism can help pinpoint sources of infection and facilitate the introduction of control measures to break transmission routes. AST informs antimicrobial prescribing and aims to increase therapeutic success. It allows a profile of mastitis pathogens recovered from a herd to be assembled and promotes proper antimicrobial stewardship.
Mastitis Diagnostics
While culture and susceptibility testing of a milk sample should be a simple procedure, there are several factors that impinge on the private veterinary practitioner (PVP) receiving a meaningful result. A frequent culture finding is contamination of the sample (Figure 1). This can be due to poor sampling technique, but by closely following the CellCheck method, a quality sample can be obtained. Samples should be delivered to the laboratory on the day of collection or by overnight delivery with an ice pack. This could be by the herd owner, a courier, or a lab vehicle which collects samples from different locations. A sample which takes several days at ambient temperature to reach the laboratory is unsuitable for testing and, if tested, may yield a contaminant which can mislead the PVP. Thus, proper sampling with prompt sample transport to the laboratory supports the isolation and identification of the causative organism.
Figure 1: Plate A displays pure growth while plate B has a mixed growth of bacteria.
AST
There are two methods commonly employed to establish the susceptibility of a bacterial isolate to an antimicrobial agent. In disc diffusion, an agar plate is inoculated with the bacterium to be tested and discs containing antimicrobials are then applied to the agar. After incubation, the zones of growth inhibition are measured, compared to published breakpoints and the bacterium classed as susceptible, intermediate or resistant (S/I/R) to that particular antimicrobial (Figure 2). Broth microdilution evaluates the capacity of the bacterium to grow in liquid media containing varying concentrations of the antimicrobials under test. The lowest concentration of a compound preventing visible growth of the bacterium is compared to published breakpoints, to determine whether that bacterium is S/I/R to that antimicrobial.
Alan Johnson would like to thank the following for their contributions to this article:
- Kevin Kenny MVB, PhD;
- Rosemarie Slowey MVB, MSc;
- Amalia Naranjo-Lucena DVM, MSc, PhD;
- Mícheál Casey MVB, MSc;
- Julie Bolton MVB, CertVPH;
- Caroline Garvan MVB, MPhil, PG Cert Food Safety, Dip Leadership, Cert Governance;
- John Moriarty MVB, DipTox; and,
- Michelle McGrath, B.Agr.Sc, M.Agr.Sc, MVB, DipSFP.
Use of antimicrobials in veterinary medicine
Antimicrobial resistance (AMR) is a key One Health challenge. Since many of the antimicrobials administered in veterinary medicine are also used in human medicine, their use in farm animals can create a reservoir of resistant organisms, lead to resistance developing in human pathogens and affect medical outcomes. To address these threats, the World Health Organization developed a list of critically important antimicrobials for use in human medicine. The European Medicines Agency considered both the risk of use in animals to public health, and the need for veterinary use, to assign antimicrobials into one of four categories. These are, A (avoid); B (restrict); C (caution) and D (prudence). DAFM, in consultation with stakeholders, developed a national policy to restrict the use of fluoroquinolones, third and fourth-generation cephalosporins and polymyxins in agriculture. These three classes and macrolides, are considered highest priority, critically important antimicrobials (HP-CIA). They should not be used prophylactically or as first line treatments and should only be considered when AST results for infected animals indicate the absence of antimicrobials in a lower priority category that could be clinically effective.
Veterinary Medicines Regulation and creation of panels for AST
The Veterinary Medicines Regulations (Regulation 2019/6) which came into force in January 2022 across all EU member states, affects prescribing and use of antimicrobials. This in turn has led to changes being made to the compounds used in AST of mastitis pathogens. Considering the available licensed products, published interpretative criteria, national policy on antimicrobial prescribing and use, and the scientific literature on mastitis therapy, DAFM and AHI have developed four core panels to test mastitis isolates. There are panels for Staphylococcus aureus; streptococci; Escherichia coli; and coagulase-negative staphylococci. Panels include antimicrobial class representatives which may predict susceptibility to other antimicrobials from within the same class (Table 1). Inhibition zones for each bacterial species and compound are interpreted as S/I/R using the internationally-recognised criteria of the Clinical and Laboratory Standards Institute (www.clsi.org). The core panels facilitate the harmonisation of testing and result interpretation and will be reviewed at intervals.
Figure 2: Zones of inhibition of bacterial growth in a disc diffusion test.

Table 1. DAFM and AHI have developed four core panels to test mastitis isolates.
Laboratory report interpretation
The laboratory report received by the PVP will record the animal identification, the identity of pathogen(s) isolated (if any), and the results of AST. The PVP should review the age of the animal, the stage of lactation and the predictive value of the antimicrobials tested when selecting therapy, recognising that in vitro susceptibility does not always ensure in vivo efficacy. Treatment failures may be due to insufficient concentrations of antimicrobial being achieved at the site of infection for an adequate period. It is prudent to advise herd owners who may expect a treatment outcome based on laboratory susceptibility, that results may sometimes be disappointing, as can happen with chronic S. aureus mastitis.
Acute severe clinical mastitis with systemic involvement can be life-threatening, especially if caused by coliform (E. coli, Klebsiella pneumoniae) bacteria and antimicrobial therapy will typically commence prior to laboratory results being available. Parenteral administration of a suitable antimicrobial, supported with non-steroidal anti-inflammatory drugs and fluids can be undertaken, with review upon receipt of the laboratory report. Where S. aureus or streptococci are suspected to be the cause, intramammary infusion of antimicrobials should also be administered.
There are two possible approaches to treatment of cases of mild to moderate clinical mastitis in dairy herds. In some herds, a standard intramammary treatment protocol, based on the herd pathogen profile, is used for all clinical mastitis cases. In such herds, it is important to collect and freeze a sample from each clinical case prior to treatment, to allow subsequent analysis be performed and the pathogen profile updated. The second approach uses a selective treatment protocol based on prompt culture results for the individual animal with mastitis. Cases of streptococcal or staphylococcal mastitis (gram-positive) receive a narrow spectrum antimicrobial by the intramammary route. Cows whose milk displays no growth or which cultures a coliform organism (gram-negative) are not treated but are monitored, since mild to moderate coliform mastitis is typically self-curing. The selective treatment approach can reduce antimicrobial use but requires prompt culture results which presents significant challenges to both the PVP and the diagnostic laboratory.
Therapy of lactating cows varies by pathogen. The bacteria most commonly isolated from Irish dairy cows are S. aureus, E. coli and environmental streptococci.
Staphylococcus aureus Clinical and subclinical S. aureus mastitis is difficult to cure. Methods used to improve bacteriological cure rates include extended intramammary therapy with or without a systemic partner. Cure rates are higher where clinical mastitis is caused by penicillin-susceptible S. aureus and around 55 per cent of Irish isolates are susceptible to penicillin. Using AST results, products containing antimicrobials from category C (caution) can be used to treat penicillin-resistant S. aureus infection. Treatment is less successful in older cows, in cows with more than one quarter infected and in cows with high SCC. Therapy of recently acquired subclinical infection during lactation can be undertaken but such infections may best be targeted at drying off using DCT selected on the basis of culture and susceptibility results. Cows with chronic infection and multiple clinical cases in a lactation are candidates for culling, but treatment in the dry period can be attempted.
Coliform mastitis
In dairy cows, coliform mastitis varies in presentation from a mild or moderate disease of limited duration to a severe acute systemic disease which can be fatal. Clinical scoring systems evaluate systemic findings and changes to the milk and mammary gland to identify cows with severe systemic disease which may have bacteraemia. Parenteral administration of a suitable antimicrobial is important in severe systemic cases, where animals are pyrexic, dehydrated and depressed with grossly abnormal milk and an inflamed mammary gland. The release of inflammatory mediators by bacterial endotoxin results in shock and administration of non-steroidal anti-inflammatory drugs and fluids are important supportive treatments.
Irish isolates of E. coli from bovine mastitis are susceptible to ampicillin (69 per cent), sulphonamide-trimethoprim (88 per cent) and amoxycillin-clavulanate (90 per cent). A study of seven dairy farms in England found a cessation in the use of HP-CIAs did not adversely affect udder health or culling rates. The intramammary treatment of non-severe clinical mastitis cases caused by E. coli may not improve the clinical outcome.
Environmental streptococci
Testing of Irish isolates of Strep. uberis and Strep. dysgalactiae found all were susceptible to penicillin. In some countries, increases in the minimum inhibitory concentrations of β-lactams for Strep. uberis isolates have been observed. This appears to relate to mutations in genes encoding penicillin binding proteins and underscores the value of monitoring susceptibility. Ampicillin and amoxicillin should achieve a better distribution in the udder after local infusion, compared to penicillin G and cloxacillin. Severe cases which do not respond to routine therapy could receive extended local therapy or parenteral administration of antimicrobial.
Coagulase-negative staphylococci (CNS)
These are also described as non-aureus staphylococci and consist of various species of the genus staphylococcus. They are recognised as a cause of clinical mastitis in first lactation animals but less so in older cows. Subclinical infections with increased SCC do arise. Staph. xylosus, Staph. chromogenes, Staph. haemolyticus and Staph. sciuri are commonly recovered. The quality of sampling can impact recovery of CNS as they can be present on teat skin. This suggests culture results for non-clinical samples be interpreted along with SCC results, or that the animal be resampled to assist the PVP establish whether an intramammary infection is present, and whether there is a need for antimicrobial treatment during lactation or at drying off.
Other pathogens
Antimicrobial treatment of summer mastitis (Trueperella pyogenes; Peptostreptococcus indolicus) affecting heifers and dry cows is unrewarding in most cases. Mycoplasma mastitis may be suspected based on clinical findings and a failure to respond to treatment. Culture or molecular tests are used to confirm infection, but the value of treatment of mycoplasma mastitis is unclear, with culling of infected cows often necessary.
Summary
The new Veterinary Medicines Regulation requires changes in the approach to prescribing of antimicrobials for treatment of bovine mastitis, which presents challenges to PVPs and to diagnostic laboratories. Culture and susceptibility results from suitable samples are invaluable tools to the PVP, both when treating mastitis and reinforcing the importance of milking hygiene, environmental hygiene, husbandry practices and biosecurity in preventing intramammary infection.
References available on request.
1. Which of the following statements are false:
A. Proper milk sample collection and prompt sample transport to the laboratory are essential to ensure an accurate laboratory result.
B. Having milk samples at ambient temperatures for several days has no effect on laboratory results.
C. The aim of AST is to increase therapeutic success and enable more prudent use of antibiotics and proper antimicrobial stewardship.
D. Disc diffusion and broth microdilution are the two methods used to establish the susceptibility of a bacterial isolate to an antimicrobial agent.
2. Which of the following statements are false:
A. In vitro sensitivity always ensures in vivo efficacy.
B. Quinolones, third and fourth generation cephalosporins, polymixins and macrolides are classed as highest priority, critically important antimicrobials (HPCIAs) by DAFM and should not be used prophylactically or as a first line of veterinary treatment.
C. Core panels have been developed to predict the susceptibility of mastitis isolates to certain antimicrobials and are available for Staphylococcus aureus, streptococci, Escherichia coli and coagulase-negative staphylococci.
D. Some acute clinical mastitis cases with systemic involvement can be life-threatening and require prompt treatment prior to the availability of laboratory results.
3. Which of the following statements are false:
A. Clinical and subclinical mastitis caused by Staphylococcus aureus is difficult to cure.
B. Cure rates are higher where clinical mastitis is caused by penicillin-sensitive S. aureus and around 55 per cent of Irish isolates are sensitive to penicillin.
C. Most Irish isolates of Escherichia coli from bovine mastitis are susceptible to ampicillin, sulphonamide-trimethoprim and amoxycillin-clavulanate.
D. Cows with chronic infection and recurring cases of mastitis during a lactation should be maintained in the herd.
4. Which of the following statements are false:
A. Environmental streptococcal isolates should be monitored for resistance to penicillin.
B. Protocols for mastitis treatment in lactating cows are the same for all pathogen types.
C. Ampicillin and amoxicillin may work better due to increased local diffusion in the udder compared with penicillin G and cloxacillin for streptococci infections.
D. Coagulase-negative staphylococci are also referred to as non-aureus staphylococci.
5. Which of the following statements are false:
A. Cases of coliform mastitis always require antimicrobial therapy.
B. Treatment with non-steroidal anti-inflammatory drugs and fluids benefits cows with severe coliform mastitis.
C. A coliform cell wall component (endotoxin) causes host cells to release inflammatory mediators which can result in shock.
D. Clinical scoring systems can be used to identify cows with severe coliform mastitis.
6. Which of the following statements are false:
A. Proper milking hygiene reduces the spread of contagious mastitis pathogens.
B. A clean environment, dry bedding, suitable cubicles and hygienic calving pens can reduce the incidence of environmental mastitis.
C. Teat dipping should only be used in problem herds.
Answers: 1B; 2A; 3D; 4B; 5A; 6C.













